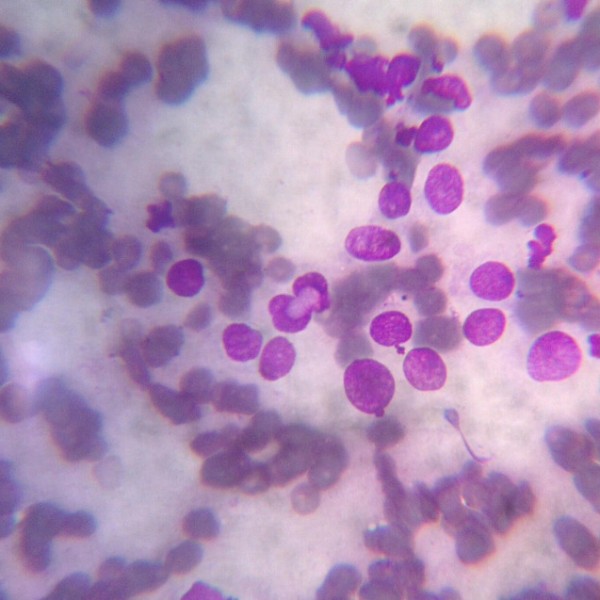

Una de nuestras principales áreas de interés es el diagnóstico y tratamiento quirúrgico y médico (quimioterapia) de los procesos tumorales en perros y gatos.
Disponemos de la experiencia y medios adecuados para diagnosticarlos y tratarlos adecuadamente en nuestra clínica.
Formación específica: La Dra. Encarnación Lozano, especialista en oncología y miembro del GEVONC, Grupo de Trabajo de Oncología de AVEPA.
Área de interés destacada para el Dr. Carlos de Mula, miembro del GEVONC, Grupo de Trabajo de Oncología de AVEPA.